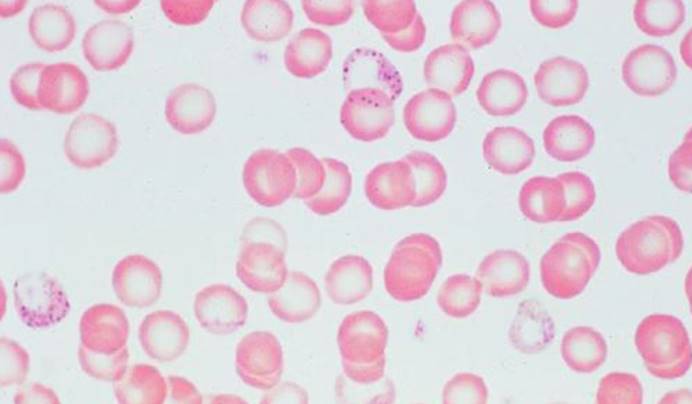
人类接触核辐射会怎么样,人接触铅对身体有害吗

审核-小文
前段时间美国一支考古团队在危地马拉北部地区对古玛雅城市遗址蒂卡尔进行考察,并且揭开了导致该城市最终被抛弃的细节原因。研究人员在蒂卡尔的水库中发现了促使这座古城走向衰落的因素,蓝细菌和重金属的污染。其中研究人员发现了古城里的朱红色壁画是导致水库出现铅超标的原因,进而可能导致该城市大部分居民出现了铅中毒的情况。

看完这则消息,估计有不少人认为蒂卡尔人之所以出现铅中毒的现象,是因为他们的城市规划不到位、饮用水供应系统不完善,但实际上如今的人类依然没有摆脱铅对生命健康的威胁。根据《纽约时报》的报道,一项最新研究指出全球大约有8亿人出现血铅超标的情况,而这8亿人则占到了儿童总数的三分之一。

该消息引起了许多国家科学家的关注,公众也想知道,什么原因导致如此多儿童存在血铅超标的情况?有什么方法可以应对这个问题吗?
铅是一种什么样的元素?
学过中学化学的朋友应该都听过“铅”这种元素,即使没学过中学化学,在一些与重金属相关的新闻资讯中也应该听过这种元素,但是大多数人只知道它会导致金属中毒。铅确实是一种金属元素,但同时它在工业上有广泛的应用,例如蓄电池、电缆、放射性防护等领域。去年,铅被列入有毒有害水污染名单中,那么它会对人体和环境造成什么样的危害呢?

人在身体最健康的情况下,体内的铅含量应该是零,但是没有人可以做到这一点,因为铅在我们生活中几乎无处不在,它们或许藏在食物中,或许藏在自来水中。进入人体后的铅有九成选择藏在骨骼中,剩下一成随着血液循环去到其他组织器官,从而影响人体健康。铅在人体内的长期积累会导致慢性中毒,比如神经系统中毒、运动系统中毒。
铅对人体健康的风险是如何产生的?
根据《纽约时报》发表的最新研究,人体接触铅的途径多种多样,而且防不胜防。例如汽车蓄电池中就含有铅,因此蓄电池生产工人则面临着可能被铅污染的风险。然后是电子产品,小到拿在手中的手机、平板电脑,大到液晶电视、冰箱等,这些电子产品一旦沦为电子垃圾,且得不到适当的处理后,将可能导致其中的铅元素流入环境中。

此外,一些化妆品和调料中也存在铅元素,这些物质的丢弃也是导致铅污染的源头。同时该研究指出,调查发现大多数儿童血铅超标的地区存在较为严重的空气污染和水体污染,而且这些地区多为发展落后国家和发展中国家。世界上发展中国家和发展落后国家的人口数量占全世界人口的大部分,因此这次的血铅超标调查反映出人类社会发展的隐患。
如何应对这一难题?
铅就像一枚硬币的两面,有好的一面也有坏的一面。如今含铅的产品已经渗透我们的生活,根本没办法把它们从我们的身边赶走。即使如此,我们对于铅污染的问题也并非无计可施。首先需要找到污染的源头,严格控制污染源,比如严格管控工业排放、严格检测含铅产品的质量等等。

当然这些应对措施学者、科学家、政府官员应该早就想到了,无奈于国家经济发展的现实情况。发展落后和发展中国家容易走上以牺牲环境为代价,甚至是以牺牲国民健康为代价来发展经济,这应该是血铅超标现象背后的主要难题。如何解决世界贫困、发展不平衡的问题,是人类未来漫长的发展道路中需要考虑的问题。
资料来源:
参考消息 7月29日 《美媒:研究称全世界三分之一儿童体内铅含量过高》